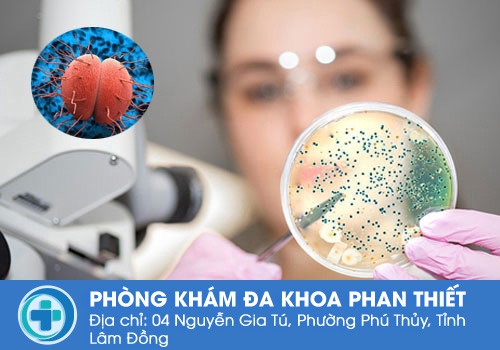

Công ty TNHH MTV dịch vụ y tế Quốc Tế Hùng Vương
02 Nguyễn Gia Tú, Khu phố 14, Thành phố Phan Thiết, Bình Thuận
Liên lạc: 0252.7303.888
Bệnh lậu từ lâu đã nổi tiếng là căn bệnh xã hội nguy hiểm, có khả năng lây nhiễm nhanh chóng. Đây là căn bệnh gây ra ảnh hưởng không chỉ sức khỏe của một cá nhân, mà còn là vấn nạn của xã hội. tuy nhiên, đến nay vẫn rất nhiều người chưa biết bệnh lậu lây truyền qua những con đường nào? Những thông tin chúng tôi chia sẻ dưới đây sẽ giúp bạn có thêm kiến thức về việc lây nhiễm bệnh lậu.
Bệnh lậu là căn bệnh nguy hiểm gây ra nhiều sự ảnh hưởng cho sức khỏe cũng như tâm lý người bệnh. căn bệnh nguy hiểm nên bệnh nhân cần phải biết bệnh lậu lây truyền qua những con đường nào, và dưới đây là những con đường lây nhiễm bệnh lậu:
Nếu bạn vô tình tiếp xúc với vết thương hở của người bị bệnh lậu, và để dính vào mặt hoặc các vết thương hở trên cơ thể mình thì nguy cơ lây nhiễm bệnh cũng rất cao. Vì thường thông qua vết thương hở này, vi khuẩn cầu lậu có thể xâm nhập vào bên trong cơ thể bạn nhanh chóng.
Đây là con đường lây nhiễm chủ yếu của bệnh lậu, có thể chiếm tới 90% số cá mắc. Bởi vì cơ quan sinh dục nam và nữ là môi trường phù hợp cho vi khuẩn lậu cư trú và phát triển. Môi trường này thường kín, ẩm ước và có độ ấm áp nên rất thuận lợi cho vi khuẩn lậu có thể sinh sôi cùng phát triển. Do đó, quan hệ tình dục không có biện pháp an toàn là nguy cơ rất cao lây nhiễm bệnh lậu.
Việc quan hệ với nhiều bạn tình, quan hệ bằng miệng, hay hậu môn, quan hệ không dùng bao cao su đều có nguy cơ lây nhiễm bệnh. Khi quan hệ, các vi khuẩn lậu sẽ xâm nhập từ người bệnh sang người kia một cách nhanh chóng.

Đặc điểm của bệnh lậu là thời gian ủ bệnh thường rất lâu, và trong thời gian này bệnh không gây ra các biểu hiện rõ ràng. Vậy nên người bệnh cũng như người xung quanh có thể vô tình không nhận ra mà lây nhiễm bệnh. Nếu bị mắc bệnh lậu mà vẫn truyền máu cho người khác thì nguy cơ lây lan là rất cao.
Nếu ai thắc mắc bệnh lậu lây truyền qua những con đường nào, câu trả lời chắc chắn không thể thiếu được qua con đường trung gian. Vi khuẩn lậu có thể sống tới vài giờ bên ngoài môi trường tự nhiên, đặc biệt là trong môi trường ẩm ướt. Vậy nên những vật dụng chứa vi khuẩn lậu như khăn tắm, khăn mặt, quần áo, bồn vệ sinh,.. nếu người bệnh sử dụng chung có thể có nguy cơ lây nhiễm bệnh rất cao.
Bệnh lậu có thể lây nhiễm từ mẹ sang con, bởi lẽ vi khuẩn lậu có thể trú ẩn ở âm đạo và cổ tử cung của người bệnh. Do vậy, nếu người mẹ bị bệnh lậu thì vi khuẩn lậu có thể lây qua thai nhi thông qua nhau thai, qua đường nước ối hoặc sinh thường. Trẻ mắc bệnh lậu thì nguy cơ dị tật, sinh non, nhẹ cân rất cao, có những trường hợp bị nhiễm trùng mắt, nhiễm trùng máu hoặc thậm chí là chưa được sinh ra đời đã gặp sảy thai trong bụng mẹ.
Biết được bệnh lậu lây truyền qua những con đường nào thì bệnh nhân cũng cần biết những biến chứng của căn bệnh này nếu như không sớm được phát hiện và điều trị. Dưới đây là những biến chứng nguy hiểm mà người bệnh có thể gặp phải khi mắc bệnh lậu:
♦ Viêm vùng chậu: Đây là biến chứng thường hay gặp ở nữ giới với nguyên nhân là do vi khuẩn lậu lây lan ở tử cung, vòng trứng và đi tới vùng chậu gây viêm. Ngoài ra lậu có thể để lại sẹo ở vòi trứng khiến cho nhiều chị em khó có thai hoặc mang thai ngoài tử cung.
♦ Viêm mắt: Vi khuẩn lậu có thể tiếp xúc và gây các bệnh về mắt như sưng, đau,… Trẻ sơ sinh mắc bệnh lậu từ mẹ có thể sinh ra đã bị mù lòa, ảnh hưởng nặng nề đến tâm lý cũng như tương lai sau này của đứa trẻ.
♦ Nhiễm trùng huyết: Vi khuẩn lậu có thể di chuyển trong hệ tuần hoàn và gây ra bệnh ở nhiều cơ qua như nhiễm trùng máu, gây nên các bệnh nổi mề đay, đau cứng khớp, sốt,…
♦ Bệnh về đường hô hấp: Vi khuẩn lậu có thể lây lan qua việc quan hệ bằng miêng, sẽ gây kích thích amidan. Và người bệnh có thể gặp các triệu chứng như đau họng, sưng họng, nuốt đau, và tăng nguy cơ mắc các bệnh về đường hô hấp.

Chính vì vậy, mọi người cần biết được bệnh lậu lây truyền qua những con đường nào để có hướng phòng tránh. Trong trường hợp nghi ngờ mắc bệnh tuyệt đối không được có tâm lý giấu bệnh, cần sớm đi gặp bác sĩ chuyên khoa để có phương án điều trị phù hợp. Bệnh lậu để lâu càng gây ra nhiều biến chứng nguy hiểm, việc điều trị cũng sẽ gặp nhiều khó khăn hơn.
Trong số những địa chỉ cơ sở y tế mà bạn có thể đặt lòng tin vào việc khám và điều trị bệnh lậu có Phòng Khám Đa Khoa Quốc Tế Hùng Vương cơ sở tại 02 Nguyễn Gia Tú, Khu phố 14, Thành phố Phan Thiết, Bình Thuận, bởi vì phòng khám có những yếu tố như:
► Phòng khám là nơi quy tụ được đội ngũ bác sĩ giỏi, có kiến thức chuyên môn, đã có nhiều kinh nghiệm. Bác sĩ thấu hiểu tâm lý bệnh nhân nên sẽ dành ra thời gian để động viên và chia sẻ giảm bớt căng thẳng và áp lực.
► Nhân viên y tế của phòng khám có thái độ tiếp đón và hướng dẫn bệnh nhân rất chu đáo, tỉ mỉ và nhiệt tình để bệnh nhân thăm khám bệnh nhanh chóng, không gặp khó khăn.
► Phòng khám có phương pháp xét nghiệm và điều trị bệnh lậu hiệu quả, bệnh nhân sẽ có cơ hội tiếp cận với công nghệ y học tiên tiến.
► Mức chi phí phòng khám rẻ và tuân theo giá của Bộ Y tế, bệnh nhân sẽ được công khai ngay từ ban đầu để lựa chọn.
► Phòng khám có thời gian khám chữa bệnh ngoài giờ, bệnh nhân có thể đi thăm khám và điều trị không ảnh hưởng công việc cá nhân, cũng như có thể đặt lịch trước.
Trên đây là những chia sẻ giúp nhiều bạn đọc biết được bệnh lậu lây truyền qua những con đường nào, cũng như nắm các biến chứng của bệnh để sớm đi thăm khám và điều trị khi thấy dấu hiệu. Nếu còn có thắc mắc nào cần được hỗ trợ có thể liên hệ đến số hotline 0252.7303.888 hoặc có thể nhấp vào Khung chat bên dưới đây để tư vấn viên giúp đỡ thêm nhé.
Phòng Khám Đa Khoa Quốc Tế Hùng Vương địa chỉ: 02 Nguyễn Gia Tú, Khu phố 14, Thành phố Phan Thiết, Bình Thuận
- Đặt lịch hẹn qua số điện thoại: 0252.7303.888 để được đăng ký khám sớm không mất công chờ đợi.
- Đăng ký ngay để nhận tư vấn và dịch vụ ưu đãi: